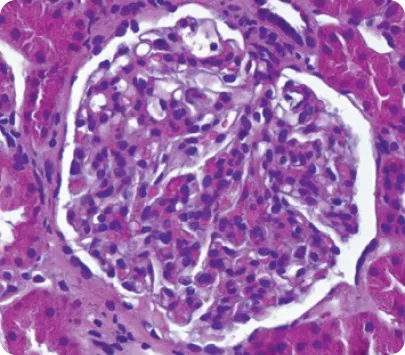
1 -Световая микроскопия

Биопсия почки в практике врача-нефролога: на что обратить внимание?
В настоящее время биопсия почки является «золотым стандартом» диагностики заболеваний паренхимы почек и обязательной диагностической процедурой при подозрении на гломерулярную патологию. Ниже будут рассмотрены общие вопросы, связанные с биопсией почек: статистические данные по нефропатологиям в России, показания и противопоказания для проведения биопсии, а также аспекты интерпретации результатов морфологического исследования.
Пожалуйста, нажмите на интересующий вас раздел, чтобы его открыть.
История и значение биопсии почки: от первого зонда
до «золотого стандарта»
С момента выполнения первой биопсии почки в 1951 году датскими нефрологами Paul Iversen и Claus Brun до внедрения исследования в клиническую практику прошло всего три года, что свидетельствует о востребованности диагностической манипуляции клиницистами. С тех пор нефробиопсия считается «золотым стандартом» диагностики гломерулярных заболеваний1. Современный морфологический анализ почечного биоптата включает световую микроскопию, иммунофлюоресцентный анализ, а также в ряде случаев электронную микроскопию.
Грамотно выполненная и интерпретированная биопсия позволяет:
Кроме того, нефробиопсия позволяет оценить выраженность иммунного воспаления, склеротических изменений в клубочках и тубулоинтерстиции. На основе полученной информации делается прогноз прогрессирования нефропатий и целесообразности проведения активной иммуносупрессивной или иной терапии для конкретного пациента, разрабатывается соответствующая тактика лечения. Распространенность различных форм почечной патологии может значительно различаться в зависимости от особенностей конкретного региона и частоты проведения биопсии1.
Неудивительно, что вовремя выполненная биопсия почки ассоциируется с замедлением прогрессирования почечной дисфункции, а также существенно увеличивает почечную выживаемость у пациентов с патологией почек12.

Приложение 1. P < 0,001.
Биопсия почки в России и мире: статистические данные
Несмотря на высокую диагностическую ценность нефробиопсии, существует общемировая проблема недостаточной частоты ее назначения. Увеличение сроков выполнения биопсии почки от первых клинических признаков патологии почек ведет к более поздней постановке диагноза и назначению лечения и зачастую приводит к ухудшению прогноза течения заболевания13.
По мнению зарубежных экспертов, к причинам низкой частоты выполнения морфологического исследования почки относятся13, 14:
Приложение 2. Количество нефробиопсий в разных странах в год на 1 миллион населения15—17.
По данным регистра ГКБ № 52 города Москва, наиболее распространенными показаниями для проведения биопсии почек были изолированный мочевой и нефротический синдром, которые стали причиной выполнения биопсии в 33% и 32,5% случаев соответственно. Почечная недостаточность была обнаружена впервые у 27% пациентов. Острый нефритический синдром отмечался как относительно редкое показание для биопсии почки (3,5%). Примерно с такой же частотой биопсия выполнялась с целью уточнения морфологической картины уже диагностированных заболеваний, в основном системной красной волчанки, ANCA-ассоциированных васкулитов, криоглобулинемического нефрита и геморрагического васкулита1.
Приложение 3. Частота встречаемости наиболее распространенных форм патологии почек1.
Важно отметить, что по результатам нефробиопсии гломерулярная патология составила 88% всех случаев. Более половины этих случаев (54%) представлены первичными гломерулопатиями, причем самой распространенной из них оказалась IgA-нефропатия, выявленная в 26,6% всех проведенных биопсий. Эти результаты соответствуют представлениям о высокой распространенности данного гломерулонефрита не только в странах Юго-Восточной Азии, где его доля составляет от 38% до 54%, но и в странах Европы, где IgA-нефропатия встречается с частотой до 35—37%1.
Необходимо отметить, что в практике врача-нефролога важно своевременно распознать профиль пациента, которому показано выполнение биопсии почки, и вовремя направить его на диагностическую процедуру. На текущий момент диагностика почечной патологии представляет собой комплексный процесс, включающий анализ клинических данных, светооптическую оценку, результаты иммунофлюоресцентного исследования, а также в некоторых случаях электронной микроскопии биоптата почки. Важно соблюдение строгих требований к методике подготовки препарата, обязательным окраскам и структуре заключения, включая описание изменений всех элементов почечной ткани1.
Показания для проведения биопсии почки
Приложение 4. Показания для проведения биопсии почки согласно зарубежным авторам2.
Основные показания к выполнению биопсии почки согласно клиническим рекомендациям МЗ РФ3:
Приложение 5. Выраженная протеинурия (более 1 г/сут) является основанием для проведения биопсии12.

Противопоказания к проведению биопсии почки
Биопсия почек — инвазивная процедура, которая может сопровождаться рисками развития осложнений, прежде всего, в форме кровотечения. В целом, осложнения биопсии, требующие серьезного врачебного вмешательства (например, хирургическое вмешательство или эмболизация), наблюдаются в 0,8% случаев. При этом частота клинически значимых кровотечений после биопсии составляет 4—7%2, 4, 5.
Противопоказания к биопсии почек связаны с индивидуальными особенностями пациента, увеличивающими риск значительного кровотечения. Ниже перечислены группы пациентов, требующие особого внимания при подготовке к проведению биопсии.
- Пациенты с неконтролируемой артериальной гипертонией, не поддающейся контролю внутривенными или пероральными антигипертензивными препаратами, — необходимо отложить биопсию до нормализации течения АГ2.
- Пациенты, получающие препараты из группы антикоагулянтов, имеют более высокий риск развития кровотечения2.
- Пациентам, получающим антикоагулянты длительно, может быть проведена нефробиопсия при условии возможности безопасно приостановить терапию на достаточное время для восстановления эффективного гемостаза2.
- Пациенты, принимающие варфарин или ингибитор фактора Xa, должны приостановить прием антикоагулянта не менее чем за 72 часа до биопсии2.
- Применение антиагрегантов также повышает риск кровотечения. Стандартной практикой является приостановка их приема за 7 дней до процедуры. Однако отсутствует подтверждение значительного снижения риска кровотечений при соблюдении этого правила2.
- Пациентам с одной почкой биопсия может быть проведена при условии возможности управления рисками путем эффективного контроля артериального давления и временного приостановления антикоагулянтной терапии2.
- Абсолютными противопоказаниями для проведения нефробиопсии являются активный инфекционный процесс, локализованный в почках, или инфекция кожи в месте введения иглы, а также невозможность эффективного взаимодействия с пациентом во время выполнения процедуры из-за когнитивных или психиатрических расстройств2.
Что необходимо морфологу для правильной интерпретации результатов?
Учитывая необходимость проведения большого количества исследований почечного биоптата, а также возможность ограниченного поражения почечных структур, например при фокальном характере поражения (фокальный некротизирующий гломерулонефрит, III класс люпус-нефрита), неадекватность полученного материала может привести к ошибочной диагностике. Для корректной интерпретации результатов биопсии необходимо: для нативной почки — минимум 10 клубочков, а для почечного трансплантата — 7 клубочков и 1 артерия10. В рамках анализа биопсийного материала проводится световая микроскопия, иммунофлюоресцентная микроскопия (ИФА) и электронная микроскопия. Наибольшую диагностическую значимость имеет ИФА.
Световая микроскопия6
ИФА6
Электронная микроскопия6
Результаты биопсии почки в практике врача-нефролога
Приложение 6. Оценка ткани почки должна соответствовать стандартам адекватности биопсии11.
Особенностью нефрологической практики является то, что каждый пациент врача-нефролога уникален. Пациенты с одинаковым клиническим течением заболевания могут иметь различные морфологические варианты поражения почек, требовать индивидуального подхода к терапии и иметь разный прогноз прогрессирования заболевания.
Биопсия почки играет ключевую роль в определении характера почечной патологии. Выявление пациентов с патологией почек, нуждающихся в проведении нефробиопсии, и их своевременное направление в экспертные диагностические центры позволяет поставить точный диагноз и назначить правильное лечение таким пациентам. В соответствии с российскими клиническими рекомендациями по лечению ХБП, патологоанатомическое исследование биопсийного материала почек должно выполняться в специализированной лаборатории для улучшения качества диагностики патологического процесса3.
Надежность результата биопсии напрямую зависит от профессионализма морфолога и оснащенности морфологического центра. Поиск опытного специалиста, способного грамотно интерпретировать результаты, — это важный этап диагностического процесса. Компетентный гистолог — ваш союзник в индивидуальном подборе терапии. Каждый шаг — от обращения к опытному морфологу до консультации в экспертной клинике и использования данных биопсии для персонализации лечения — играет свою роль в формировании успешного и индивидуализированного подхода к лечению заболеваний почек.
Список сокращений
ГКБ — городская клиническая больница;
МН — мембранозная нефропатия;
БМИ — болезнь минимальных изменений;
ФСГС — фокальный сегментарный гломерулосклероз;
ЭКГН — экстракапиллярный гломерулонефрит;
ТМА — тромботическая микроангиопатия;
ГНАС — гипертонический нефроангиосклероз;
СКВ — системная красная волчанка;
ТИН — тубулоинтерстициальный нефрит;
ОКН — острый канальцевый некроз;
СКФ — скорость клубочковой фильтрации;
ИФА — иммуноферментный анализ;
AA — амилоид A;
ГБМ — гломерулярная базальная мембрана;
DNAJB9 — 9-й белок семейства В-гомологов DnaJ;
ГН — гломерулонефрит;
IgA — иммуноглобулин A;
IgG — иммуноглобулин G;
IgM — иммуноглобулин M;
LECT2 — хемотаксин-2, полученный из лейкоцитарных клеток;
PLA2R — рецептор фосфолипазы A2М-типа;
THDS7A — тромбоспондин-1, содержащий домен 7A.
Список литературы
- Столяревич Е.С., Жилинская Т.Р., Варясин В.В. Морфологическая структура почечной патологии: данные 7 лет наблюдения. Нефрология и диализ. 2021; 23(3):379-389.
- Randy L. Luciano and Gilbert W. Moeckel. Update on the Native Kidney Biopsy: Core Curriculum 2019. Am J Kidney Dis. 73(3): 404-415.
- Клинические рекомендации «Хроническая болезнь почек (ХБП)». Рубрикатор клинических рекомендаций. [Электронный ресурс]. URL: https://cr.minzdrav.gov.ru/recomend/469_2 Дата последнего обращения: январь 2024 г.
- Korbet S.M. Percutaneous renal biopsy. Semin Nephrol 22: 254–267, 2002.
- Corapi KM Bleeding complications of native kidney biopsy: A systematic review and meta-analysis. Am J Kidney Dis 60: 62–73, 2012.
- Sethi S et al. Kidney Int. 2009;75:952-960.
- Smith RJH et al. Nat Rev Nephrol. 2019;15:129-143.
- Haas M. J Am Soc Nephrol 8:70,1997.
- Rivera A. Meleg-Smith S Ultrastruct Pathol 25:313,2001.
- Corwin et al., Am J Nephrol 1988.
- Перевод на русский язык Клинических практических рекомендаций KDIGO 2021 по лечению гломерулярных болезней. И.Н. Бобкова, Н.М. Буланов, Е.В. Захарова, А.Ю. Земченков, Е.С. Камышова, Е.В. Паршина, Л.С. Приходина, А.Д. Путинцева, А.Н. Шведова, под общей редакцией Е.В. Захаровой. Нефрология и диализ. 2022. 24(4):577-874.
- Zhang T, Yang X, Zhang M, Zhou W, Jin Y, Zhou H, Zhou Y, Wang Q, Mou S. Effects of receiving renal biopsy on the prognosis of chronic kidney disease patients with impaired renal function. BMC Nephrol. 2023 Mar 15;24(1):56. doi: 10.1186/s12882-023-03097-2. PMID: 36922798; PMCID: PMC10018988.
- Amodu A, et al. Nephrologists' Attitudes Toward Native Kidney Biopsy: A Qualitative Study. Kidney Med. 2021 Sep 22;3(6):1022-1031.
- Molnár A, et al. Kidney biopsy-based epidemiologic analysis shows growing biopsy rate among the elderly. Sci Rep. 2021 Dec 29;11(1):24479.
- Heaf J. The Danish Renal Biopsy Register. Kidney Int. 2004 Sep;66(3):895-7.
- Cunningham A, Benediktsson H, Muruve DA, Hildebrand AM, Ravani P. Trends in Biopsy-Based Diagnosis of Kidney Disease: A Population Study. Can J Kidney Health Dis. 2018 Sep 20;5:2054358118799690.
- Fiorentino M, et al.. Renal Biopsy in 2015--From Epidemiology to Evidence-Based Indications. Am J Nephrol. 2016;43(1):1-19.
Полезные материалы
11376906/IPT/DIG/03.25/1